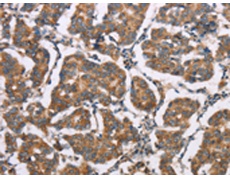
一抗

|
Background: |
ELP3 is the catalytic subunit of the histone acetyltransferase elongator complex, which contributes to transcript elongation and also regulates the maturation of projection neurons. Catalytic histone acetyltransferase subunit of the RNA polymerase II elongator complex, which is a component of the RNA polymerase II (Pol II) holoenzyme and is involved in transcriptional elongation. Elongator may play a role in chromatin remodeling and is involved in acetylation of histones H3 and probably H4. May also have a methyltransferase activity. Involved in cell migration. |
|
Applications: |
ELISA, IHC |
|
Name of antibody: |
ELP3 |
|
Immunogen: |
Synthetic peptide of human ELP3 |
|
Full name: |
elongator acetyltransferase complex subunit 3 |
|
Synonyms: |
KAT9 |
|
SwissProt: |
Q9H9T3 |
|
ELISA Recommended dilution: |
1000-2000 |
|
IHC positive control: |
Human breast cancer |
|
IHC Recommend dilution: |
25-100 |

 購(gòu)物車(chē)
購(gòu)物車(chē) 幫助
幫助
 021-54845833/15800441009
021-54845833/15800441009